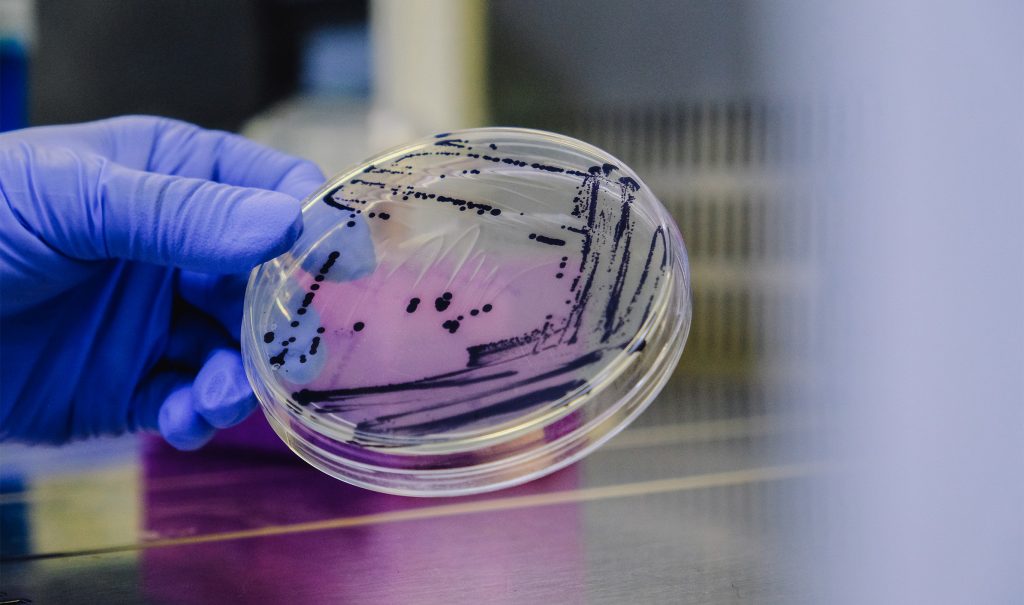

意大利家族纺织品集团 Albini 宣布,旗下工业与科学创新部门 Albini_next 与英国生物技术公司 Colorifix 合作推出 “Exteria—细菌染色” 试点项目。
该项目由 Albini 集团和法国时尚巨头 Kering 开云集团的材料研发所 (Material Innovation Lab,简称 MIL)赞助,利用合成生物学技术研发出的工程微生物对纺织品进行染色。
在 Albini 与 Colorifix 两家发表的联合声明中,这一项目被誉为使“可持续性时尚”从理念转变为现实的开创性发明:Colorifix 的技术通过基因测序精确识别出动植物或昆虫体内产生色素的基因,将其编入微生物的DNA,令其以纯天然的方式产出色素。该项技术可以大幅节省水与能源,彻底杜绝染色过程中有害化学物质的产生。




